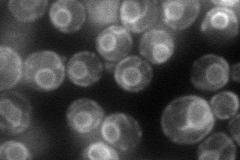
YCR048W
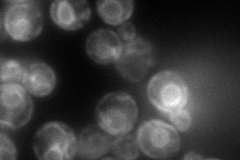
YCR048W
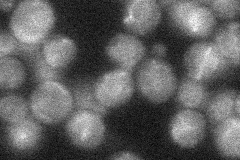
YCR048W

View description
Acyl-CoA:sterol acyltransferase, isozyme of Are2p; endoplasmic reticulum enzyme that contributes the major sterol esterification activity in the absence of oxygen
Localization:
Intensity:
Fold change:
Significance:
-
C’ GFP library in SD

ER20.67 -
N' NOP1pr-GFP in SD
ER87.7294 -
N' TEF2pr-mCherry in SD
ER114.385 -
N' NATIVEpr-GFP in SD
ER21.2915 -
N' TEF2pr-VC and Cyto-VN in SD

ER47.0121 -
C’ GFP library in SD+DTT

ER19.290.93No -
C’ GFP library in SD+H2O2

ER23.41.13No -
C’ GFP library in Starvation Media

ER18.730.9No -
C’ GFP library on the background of Pup2-DaMP

ER -
C’ GFP library on the background of CCT mutant

ER18.84130.91116No
